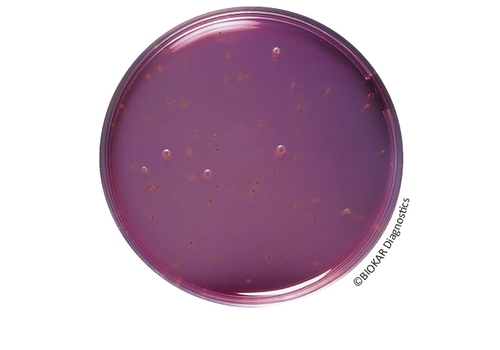

Bacillus

Bacillus Cereus Agar (ACC. TO MOSSEL)
Bacillus Cereus Agar (ACC. TO MOSSEL) Bacillus cereus Agar is used for the detection and..
More
BCP Dextrose Tryptone Agar
BCP Dextrose Agar BCP Dextrose Tryptone Agar (also known as BCP Glucose agar) is used to..
More
COMPASS® Bacillus Cereus Agar
COMPASS® Bacillus Cereus Agar COMPASS® Bacillus cereus Agar is a solid medium used for the..
More
Tryptone-Soy Agar
Tryptone-Soy Agar Tryptone-Soy Agar, used as a base to be supplemented with blood, is prepared..
More